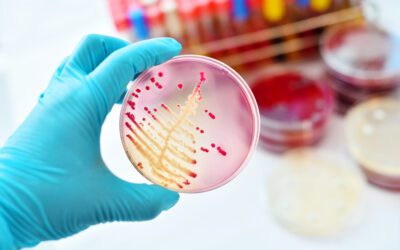
How Cosmetics Microbiology Testing Supports Product Safety and Quality

So The World Can Trust In What It Consumes™
Certified Laboratories partners with customers to deliver innovative scientific solutions and expertise in support of the food & beverage, cosmetic, OTC, supplements, and other regulated industries.
Laboratory Testing & Other Services
Analytical Chemistry
Validated methods to verify product safety in compliance with FDA, USDA, AOAC, and USP standards for the food & beverage, cosmetic, OTC, and supplement industries.
Microbiology
Extensive lab testing capabilities to detect pathogens, indicators, spoilage organisms, toxins, and other contaminants in food & beverage, cosmetic, OTC, supplement, and other consumer products.
FDA Import
Services to help get your products released quickly from FDA detention.
Food Safety Training
Virtual (live, instructor-led) and in-person food safety training from the experts at Food Safety Net Services, a Certified Group company.
EMP Software
Save time and streamline your Environmental Monitoring Program with emma®, our proprietary Environmental Monitoring and Mapping Application provided by Food Safety Net Services.
Certification & Audit
Separate from our Regulatory Consulting services, our team offers a broad range of food safety, animal welfare, GMP, and other certification and audit services.
Regulatory Consulting
Separate from our Certification & Audit services, our team provides regulatory consulting services to help ensure you meet FDA, USDA, and other regulatory requirements.
Contract Research
Shelf-life studies, challenge studies, process validations, microbial strain typing, and other contract research services to support your food safety and quality programs, available from FSNS Lab+.
Industries
Food & Beverage
Certified Laboratories and Food Safety Net Services work together under the Certified Group banner to provide a broad range of microbiology, analytical chemistry, nutritional analyses, contract research, and other services for manufacturers and distributors in the food and beverage industry. Our 30+ ISO 17025-accredited testing laboratories test beverages, dairy, protein, ready-to-eat products, pet food, nuts & spices, seafood, produce, and more.
Cosmetics, OTC, & Supplements
Certified Laboratories provides expert testing services for the cosmetic, over-the-counter (OTC), and dietary supplements industries. Our comprehensive offerings include microbiology, chemistry, in-package stability/compatibility studies, preservative effectiveness, and more, all performed with advanced equipment and validated methods. We ensure compliance with FDA, cGMP, ISO, and Health Canada standards, verifying product safety, purity, and performance.
Cannabis & Hemp
Certified Laboratories provides expert, compliant cannabis and hemp lab testing. Our ISO 17025-accredited and DEA-registered laboratories ensure accurate, defensible results. With multiple locations also holding cGMP certification, we uphold the highest industry standards for more reliable results. Our services include potency analysis, contaminant screening, terpene profiling, stability studies, and more using validated methods and advanced instrumentation.





Why Choose Certified Laboratories
for Your Laboratory Testing?
As part of Certified Group, Certified Laboratories provides comprehensive laboratory testing services across regulated industries. In partnership with Food Safety Net Services, we provide analytical chemistry and microbiology testing for the food and beverage industry.
We also serve the cosmetic, over-the-counter (OTC) drug, and supplements industries. Our accredited testing laboratories deliver accurate, reliable results to support your safety and quality programs.
- Competitive TAT
- Turn-key pricing
- North American network of 30+ ISO 17025-accredited labs
- 24/7/365 dedicated, reliable service
- Direct access to your experienced lab manager and technical team
- Real-time data access
- Flexible courier service
- Comprehensive range of lab services
Latest News
Phil Gillespie Named Chief Financial Officer of Certified Group
New CFO to Support Company’s Growth and TIC Market Expansion SAN ANTONIO, Texas – Sept. 8,...
Food Safety Net Services (FSNS) Expands with New Laboratory in St. Louis
Bringing 24/7 Food Safety Testing to the Area SAN ANTONIO, Texas, March 3, 2025 – Food...
Food Safety Net Services (FSNS) Announces Valentine’s Promotion on 2025 Food Safety Training
Register Between Feb. 14-28 for 20% Off All Courses SAN ANTONIO, Feb. 14, 2025 /PRNewswire/...
Read the Blog
How Cosmetics Microbiology Testing Supports Product Safety and Quality
Reviewed and Approved by Richard A. Boehler, Jr., MSc., Cosmetic Microbiology Laboratory Manager,...
How to Read an FDA Notice of Action (NOA)
Reviewed and Approved by Tim Lombardo, Sr. Dir. of Food Consulting Services, EAS Consulting Group;...
Ido-BR1 Testing for Dietary Supplements: New Validated Method
Reviewed and Approved by Matt Traynor, PhD, Vice President, Innovation and Validation, Certified...
Health Canada’s NHP GMPs 4.0: Stability Testing FAQs
Reviewed and Approved by Matilda Baghdasarian, Laboratory Services Associate Director ...
A Certified Group Company
Certified Group partners with customers to deliver innovative scientific solutions and expertise – So The World Can Trust In What It Consumes™. Our network of 30+ North American and European laboratories serves the food & beverage, dietary supplements, cosmetics, OTC, tobacco/nicotine, cannabis, and hemp industries.
We combine the technical expertise and breadth of services you expect from a large testing laboratory with the personalized service of your local lab.
Begin Your Laboratory Testing Now
Submit the form to get a quote for your food & beverage, cosmetic, OTC, supplements, or other consumer product testing needs!
Certification & Audit and Regulatory Consulting are separate entities. Use of Regulatory Consulting services does not provide an advantage nor is it linked to the granting of Certification.